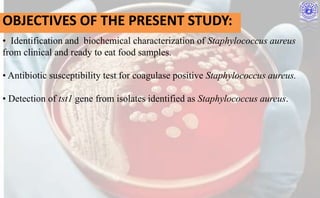
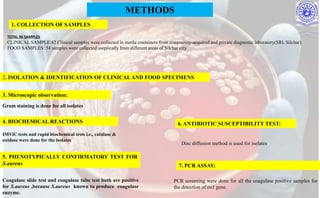

How to identify Staphylococcus aureus using the Coagulase Test - Slide and Tube Method - 4K
Por um escritor misterioso
Last updated 28 março 2025

identification and characterization of Staphylococuss. aureus from

Coagulase Test

Coagulase Test, Staphylococcus aureus detection

laboratory diagnosis of staphylococcus
identification and characterization of Staphylococuss. aureus from

Coagulase Test: Principle, Procedure, Results • Microbe Online

Coagulase Test for Staphylococcus

Identification of Staphylococcus
Andrea Longshore on LinkedIn: I know there are some very talented

Staphylococcus aureus

Bacterial Coagulase Test: Introduction, Principle, Procedure

Coagulase Test Principle, Procedure, Application, Result.

Staphylococcus aureus

Staphylococcus spp
Recomendado para você
-
Staphylococcus - Wikipedia28 março 2025
-
Staphylococcus aureus - Wikipedia28 março 2025
-
Taming Staphylococcus aureus in the eczema skin microbiome28 março 2025
-
Staph infection-induced kidney disease may be linked to bacterial gene mutation28 março 2025
-
MRSA (Methicillin-Resistant Staphylococcus Aureus) Infection - Willis-Knighton Health System28 março 2025
-
Staphylococcus aureus28 março 2025
-
Staphylococcus aureus: A Blemish on Skin Immunity: Cell Host & Microbe28 março 2025
-
Staphylococcus aureus host interactions and adaptation28 março 2025
-
Research aims to prevent resistance to staph infection treatment28 março 2025
-
Staphylococcus aureus Orchestrates Type 2 Airway Diseases: Trends in Molecular Medicine28 março 2025
você pode gostar
-
Chad Base NFT floor price and value28 março 2025
-
Maquiagem e salão de beleza para meninas : jogo de Spa para a28 março 2025
-
Silvo Spice Mix - Stamppot Hutspot 25g - The Dutch Shop28 março 2025
-
Stream Spectraali, ℵiℊ♄т¢øґ℮28 março 2025
-
Subdomain dynamics enable chemical chain reactions in non-ribosomal peptide synthetases28 março 2025
-
Warriors: The New Prophecy #1: Midnight by Erin Hunter28 março 2025
-
HE'S THE KING?! Blue Lock Episode 3 REACTION28 março 2025
-
Pin by wilT Ta on Mbti Mbti relationships, Mbti personality, Mbti character28 março 2025
-
Blox Fruit Gacha Chance28 março 2025
-
Uncharted 3: Drake's Deception (Game Of The Year Edition) Price in India - Buy Uncharted 3: Drake's Deception (Game Of The Year Edition) online at28 março 2025